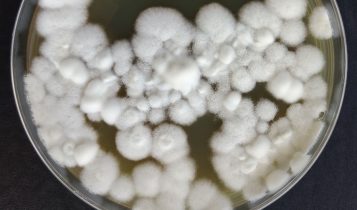
Com edição genética, fungo ganha mais eficácia no controle de pragas agrícolas

CATEGORIA
Notícias
Imposto de renda pessoa física: Prazo para declaração começa hoje
Programa para declaração do Imposto de Renda já está disponível para download! Veja as regras para envio dos documentos
Com edição genética, fungo ganha mais eficácia no controle de pragas agrícolas
O estudo, uma prova de conceito com a tecnologia CRISPR-Cas9, destacou como a alteração do gene Bbsmr1 impulsiona a capacidade do fungo em eliminar insetos.
Exportações de carne dos EUA ficam em risco com vencimento de licenças da China
Prazo de autorizações de plantas americanas responsáveis por US$ 3 bi em exportações termina na segunda-feira; JBS está entre as empresas afetadas
Alta do feijão carioca é destaque; safra 24/25 deve crescer 1,5%
A produção nacional de feijão da safra 2024/25 deve atingir 3,3 milhões de toneladas, crescimento de 1,5% em relação ao ciclo anterior.
Vídeo: homem é encurralado por mais de 20 porcos-do-mato
O homem gravou o momento, que viralizou nas redes sociais e já conta com mais de 124 mil curtidas no Instagram, e não ficou ferido, mas teve que subir em uma cerca para se proteger dos porcos-do-mato
Vai chover hoje? Veja a previsão do tempo completa
Confira as regiões do país que podem ter pancadas de chuva nesta segunda-feira, segundo a Climatempo
FAO: alta no preço do café reflete clima que afeta oferta do Brasil e do Vietnã
No Brasil, o clima quente e seco levou a repetidas revisões para baixo da safra, com as estimativas oficiais de produção passando de um aumento anual de 5,5% na temporada anterior para uma queda de 1,6%.
Seca reduz umidade do solo e exige monitoramento na safrinha do milho
A precipitação acumulada desde o início de fevereiro atingiu o menor nível em 30 anos, enquanto temperaturas elevadas aceleraram a evapotranspiração no Centro-Sul do País.
Estudo revela que solo bem manejado resiste a queimadas e mantém produtividade
Grupo GoGenetic, Fazenda Tropical e Syncbio demonstram que o manejo adequado do solo foi fundamental para mitigar danos do fogo.
Título de melhor cowboy do mundo da PBR segue pegando fogo; veja onde está o Brasil
Com um desempenho perfeito de 3 montarias qualificadas em 3 tentativas, Kasel reduziu significativamente a diferença para o líder do ranking mundial do título de melhor cowboy do mundo da PBR, Brady Fielder